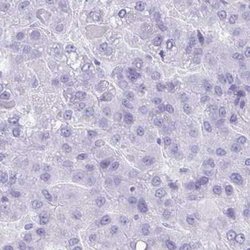

Antibody data
- Antibody Data
- Antigen structure
- References [0]
- Comments [0]
- Validations
- Immunohistochemistry [3]
Submit
Validation data
Reference
Comment
Report error
- Product number
- ABIN4352470 - Provider product page

- Provider
- antibodies-online
- Product name
- anti-Sel-1 Suppressor of Lin-12-Like 2 (C. Elegans) (SEL1L2) antibody
- Antibody type
- Polyclonal
- Description
- Immunogen affinity purified
- Reactivity
- Human
- Host
- Rabbit
- Isotype
- IgG
- Vial size
- 0.1 mL
- Storage
- Store at 4°C short term. Aliquot and store at -20°C long term. Avoid freeze-thaw cycles.
No comments: Submit comment
Supportive validation
- Submitted by
- antibodies-online (provider)
- Main image
- Experimental details
- IHC
- Submitted by
- antibodies-online (provider)
- Main image

- Experimental details
- IHC
- Submitted by
- antibodies-online (provider)
- Main image

- Experimental details
- IHC